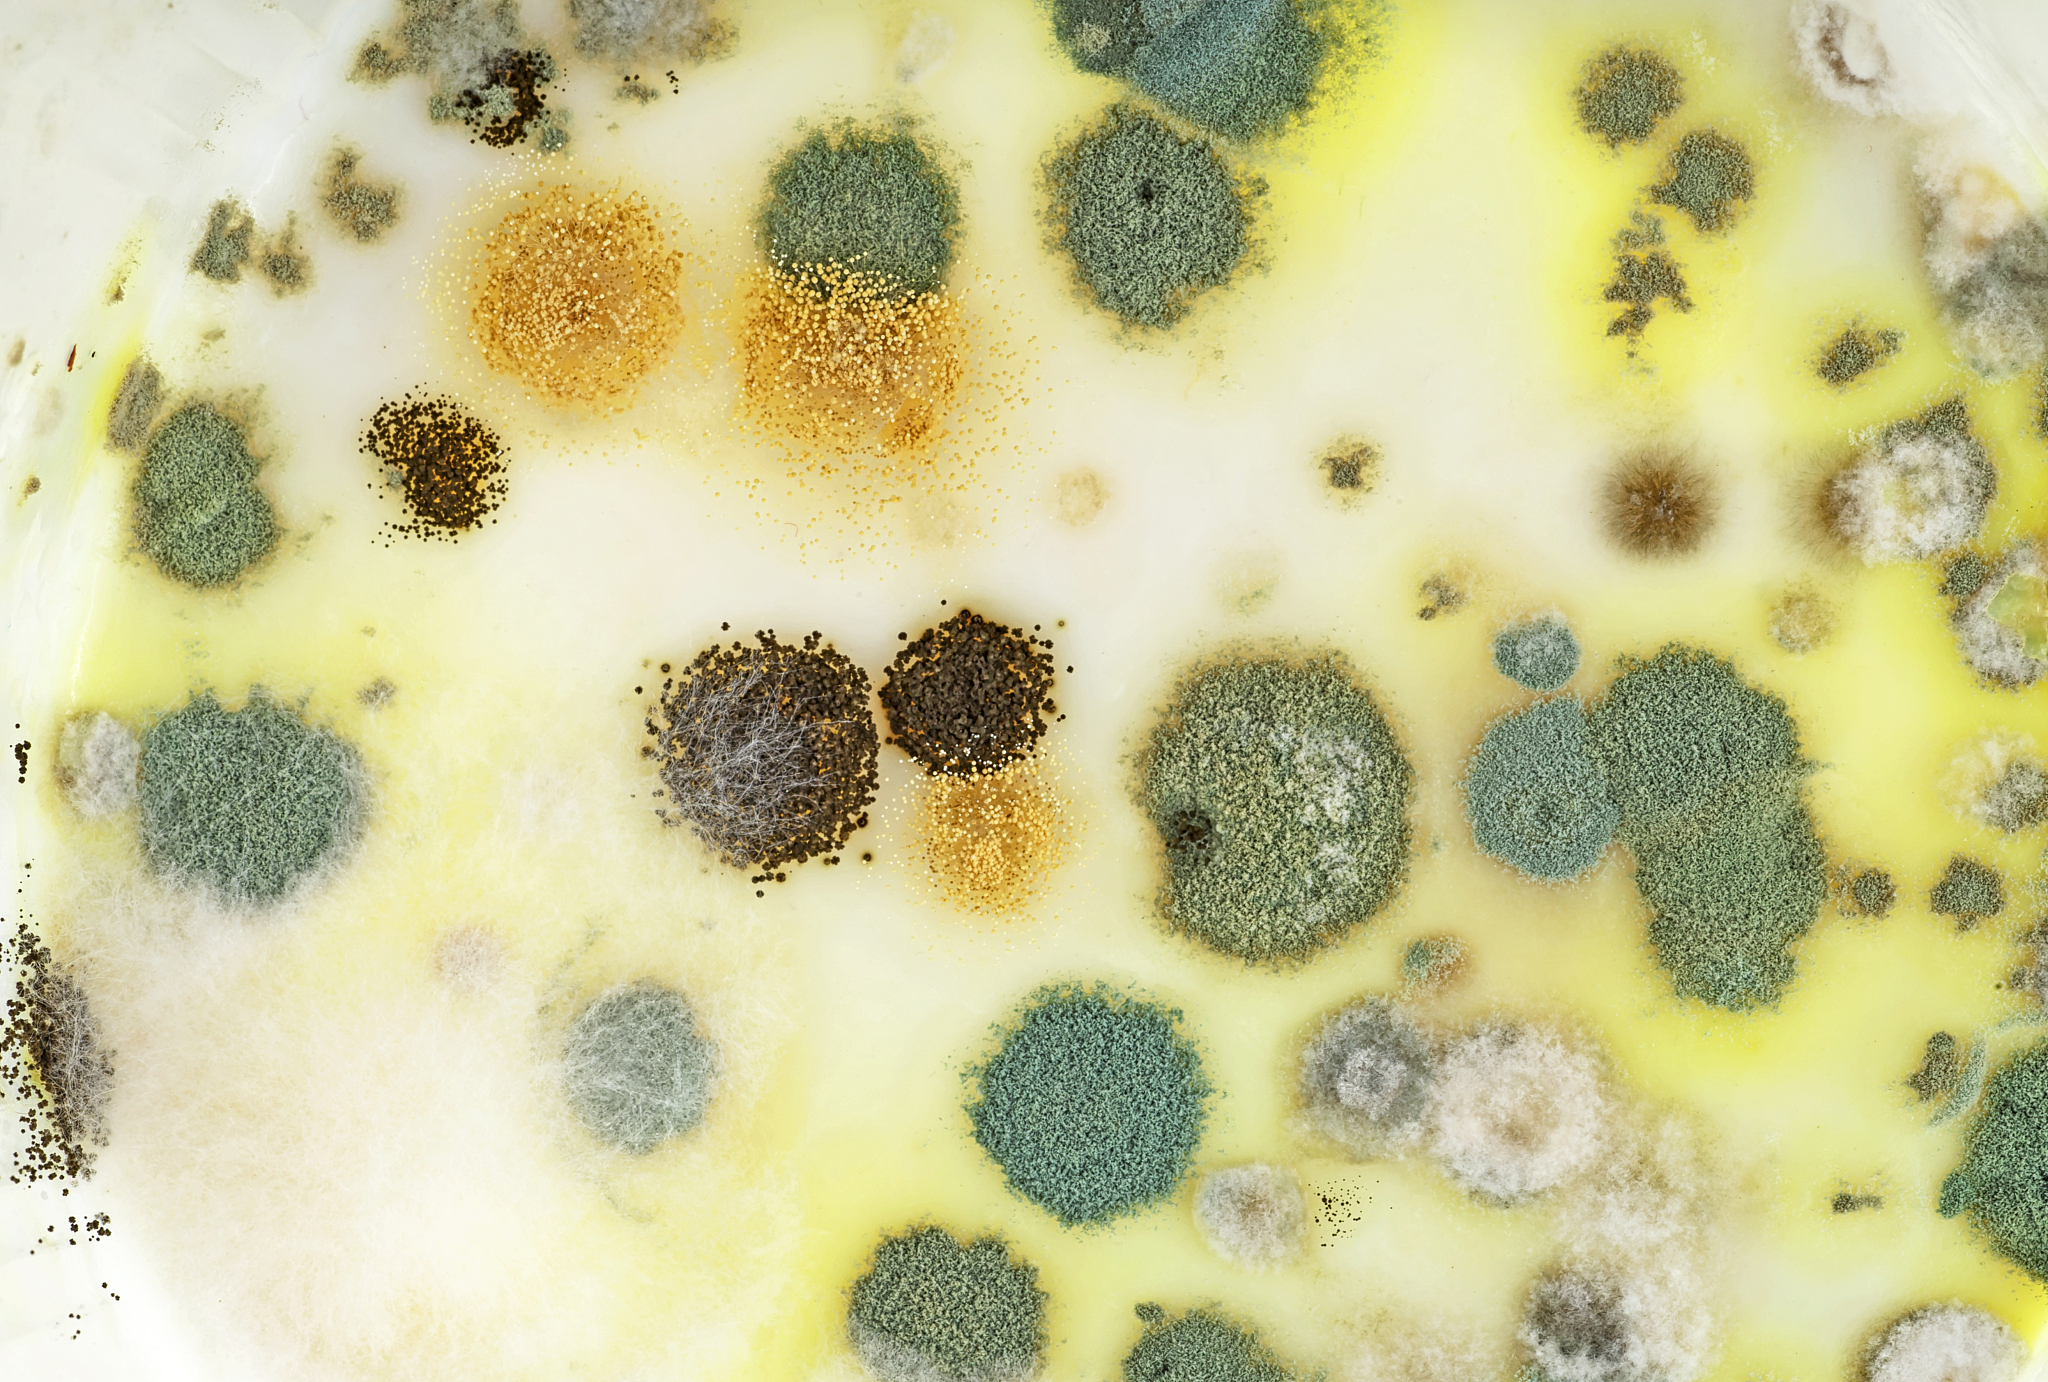
大豆堆微生物颜色差异：白色表面 vs 灰黄色内部

大豆堆微生物颜色差异:白色表面 vs 灰黄色内部
大豆堆表面上长得微生物是白色的可能是白色念珠菌等真菌,表面以下往往是灰黄色的可能是青霉菌等真菌。这是因为表面上的真菌更容易受到空气中的氧气和光照的影响,而表面以下的真菌则更容易受到温度和湿度的影响。不同的真菌在不同的环境条件下生长,因此会表现出不同的颜色。

原文地址: https://www.cveoy.top/t/topic/jM6N 著作权归作者所有。请勿转载和采集!
安全问答是一个知识全球问答,包含丰富的问答知识
大豆堆表面上长得微生物是白色的可能是白色念珠菌等真菌,表面以下往往是灰黄色的可能是青霉菌等真菌。这是因为表面上的真菌更容易受到空气中的氧气和光照的影响,而表面以下的真菌则更容易受到温度和湿度的影响。不同的真菌在不同的环境条件下生长,因此会表现出不同的颜色。
原文地址: https://www.cveoy.top/t/topic/jM6N 著作权归作者所有。请勿转载和采集!